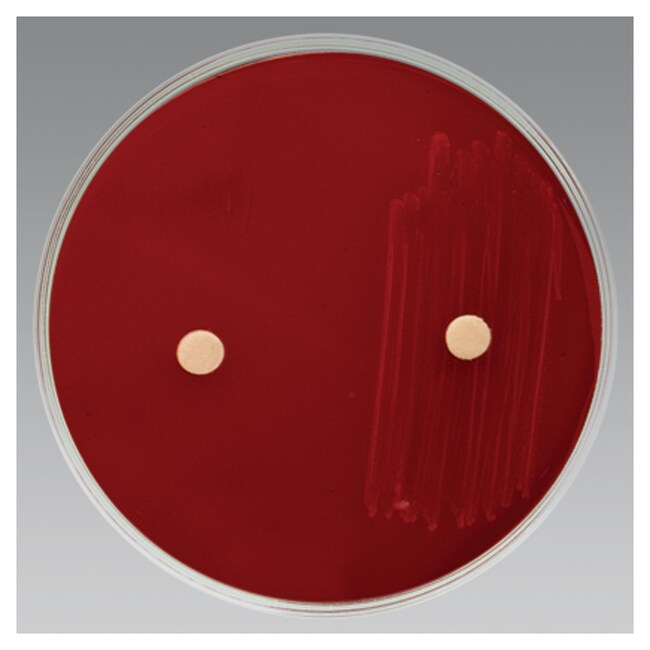
卡那霉素纸片

Search
Search
使用本款即用型卡那霉素浸渍纸片,可确认革兰氏染色反应,并推定性鉴定厌氧、革兰氏阴性杆菌。
| 货号 | 数量 |
|---|---|
| R21126 | 25 片/瓶 |
使用 Thermo Scientific™ Remel™ 卡那霉素纸片,可确认厌氧菌的革兰氏染色反应,并推定性鉴定厌氧、革兰氏阴性杆菌。
1971 年,Sutter 和 Finegold1 推荐了一种基于抗生素应答差异来鉴定厌氧、革兰氏阴性杆菌的方法。因此,可以根据微生物与红霉素、利福平、粘菌素、青霉素、卡那霉素和万古霉素的特征性抑制模式对其进行分群2,3。
使用卡那霉素纸片推定性鉴定厌氧菌。3,4
卡那霉素纸片含有 1000 µg 卡那霉素。
使用红霉素、利福平、粘菌素、青霉素、卡那霉素和万古霉素浸渍的纸片可根据其呈现出的抑制区域,用于鉴定厌氧、革兰氏阴性杆菌。粘菌素和万古霉素可确认革兰氏染色反应,有助于鉴定革兰氏染色阴性的梭菌。青霉素、利福平和卡那霉素可区分拟杆菌和梭杆菌。
并非所有产品在所有国家(地区)均有售。详情请具体咨询。
Remel™ 和 Oxoid™ 产品现已归属 Thermo Scientific 品牌旗下。